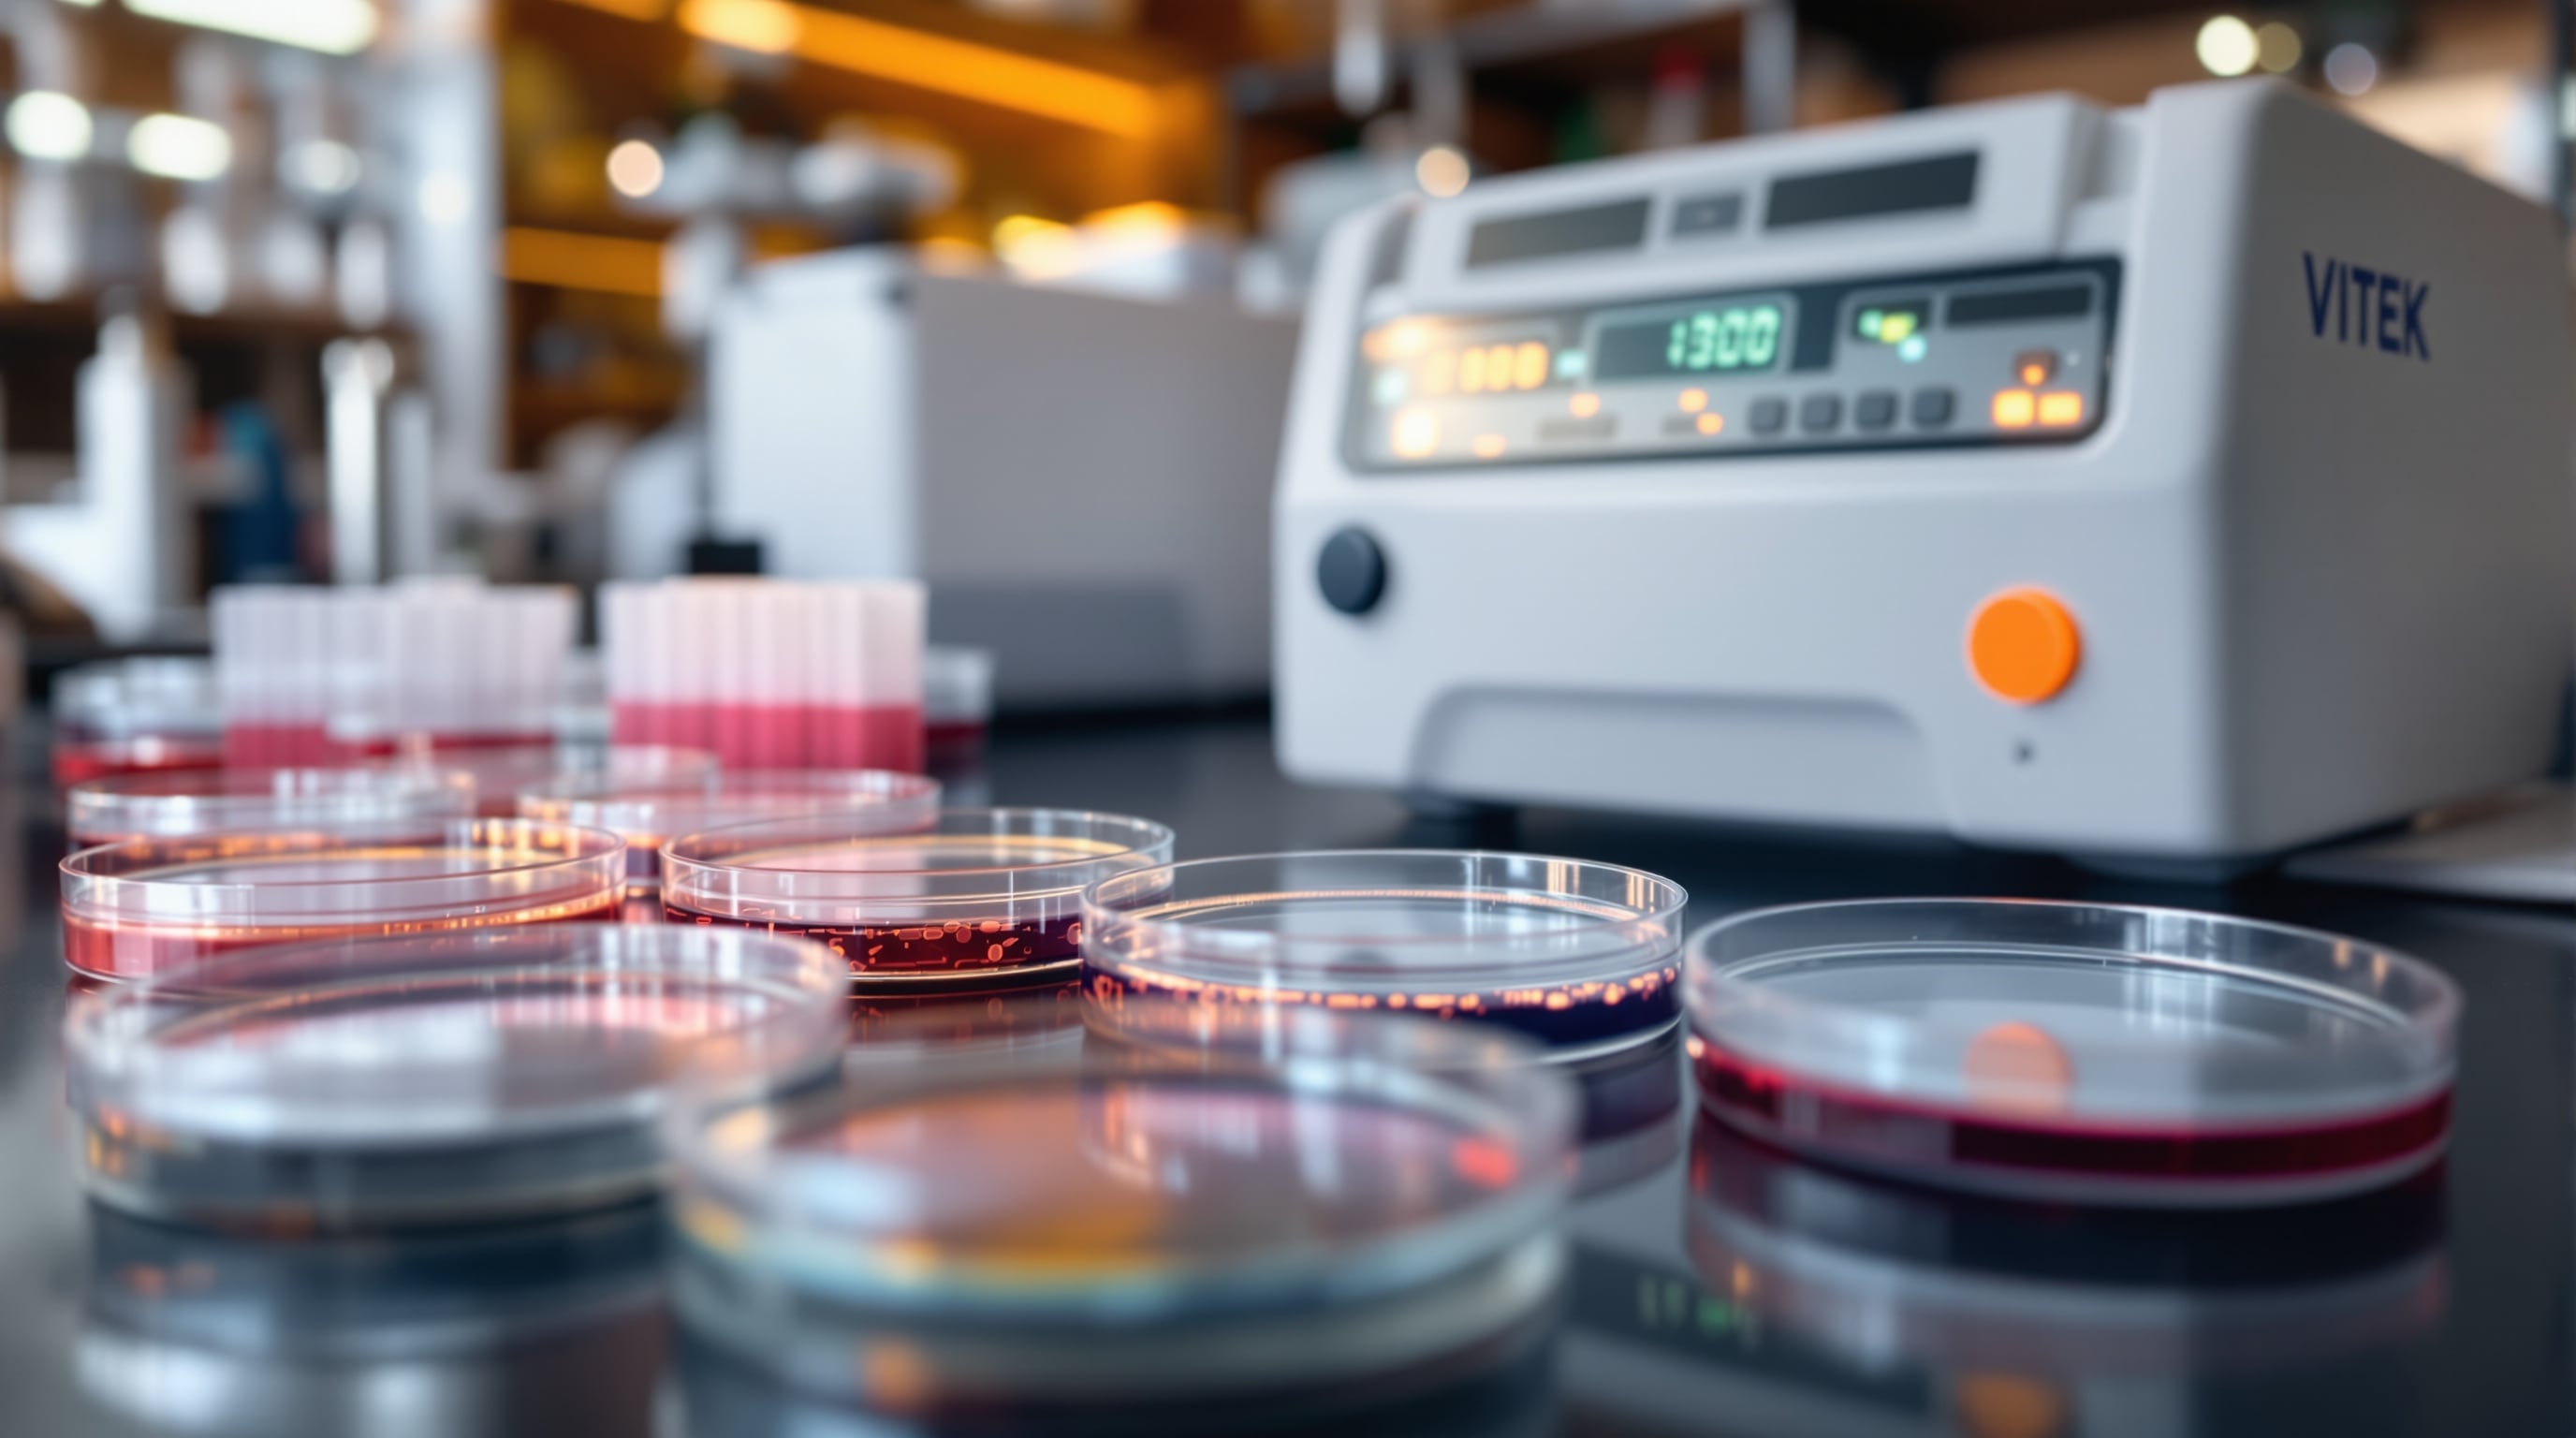
Антимикробная резистентность: роль лаборатории в мониторинге и борьбе с АМР

Антимикробная резистентность: роль лаборатории в мониторинге и борьбе с АМР
Антимикробная резистентность (АМР) признана Всемирной организацией здравоохранения одной из десяти главных глобальных угроз здоровью. По оценкам, к 2050 году АМР может стать причиной до 10 миллионов смертей ежегодно. Клиническая микробиологическая лаборатория играет центральную роль в мониторинге и контроле резистентности — от определения чувствительности отдельных изолятов до формирования антибиограмм учреждения.
В этой статье разберём роль лаборатории в борьбе с АМР, методы определения антибиотикочувствительности, молекулярные подходы и организацию мониторинга.
Масштаб проблемы
Глобальная статистика
- В 2019 году АМР стала причиной 1,27 миллиона смертей напрямую и ассоциирована с 4,95 миллионами смертей;
- Метициллинорезистентный S. aureus (MRSA) — один из наиболее проблемных патогенов;
- Карбапенемрезистентные энтеробактерии (CRE) угрожают «последней линии обороны»;
- Мультирезистентный туберкулёз (MDR-TB) — особая проблема для Центральной Азии.
Региональная специфика
Для стран Центральной Азии и Кавказа характерны:
- Высокая распространённость MDR-TB и XDR-TB;
- Неконтролируемое использование антибиотиков (безрецептурная продажа);
- Недостаточный охват микробиологической диагностикой;
- Дефицит данных по региональным паттернам резистентности.
Методы определения антибиотикочувствительности
Фенотипические методы
#### Диско-диффузионный метод (Кирби-Бауэра)
Классический метод, рекомендованный EUCAST и CLSI:
#### Метод серийных разведений
Определение МИК — количественная характеристика чувствительности:
#### Автоматизированные системы
Автоматизированные платформы для идентификации и определения чувствительности:
| Система | Производитель | Время | Особенности |
|---|---|---|---|
| VITEK 2 | bioMérieux | 4–18 ч | Идентификация + АТ, наиболее распространена |
| MicroScan | Beckman Coulter | 4–18 ч | Панели для грамположительных и грамотрицательных |
| BD Phoenix | BD | 6–16 ч | Технология RedOx |
| Sensititre | Thermo Fisher | 18–24 ч | Золотой стандарт бульонного микроразведения |
- Низкая стоимость и простота;
- Качественный результат (S/I/R);
- Не определяет МИК (минимальную ингибирующую концентрацию);
- Требует 16–24 часа инкубации.
- Бульонное микроразведение — референсный метод EUCAST/CLSI;
- Е-тест (градиентная диффузия) — полоска с градиентом концентраций;
- Результат: точное значение МИК в мкг/мл.
Молекулярные методы
Молекулярная детекция генов резистентности обеспечивает быстрый результат:
- ПЦР-детекция генов резистентности — mecA (MRSA), vanA/vanB (VRE), карбапенемазы (KPC, NDM, OXA-48);
- Мультиплексные панели — BioFire Blood Culture Panel определяет 6 генов резистентности;
- WGS (полногеномное секвенирование) — полная картина всех генов резистентности;
- MALDI-TOF с быстрым тестом на резистентность — детекция карбапенемаз за 30–60 минут.
Организация мониторинга АМР
Антибиограмма учреждения
Ключевой инструмент рационального назначения антибиотиков:
- Кумулятивные данные по чувствительности за 12 месяцев;
- Разделение по типам образцов (кровь, моча, раневое отделяемое);
- Минимум 30 изолятов на комбинацию «возбудитель — антибиотик»;
- Ежегодное обновление и распространение среди клиницистов.
Программа управления антибиотиками (AMS)
Лаборатория — ключевой партнёр в программе AMS:
- Быстрая идентификация возбудителя (MALDI-TOF, молекулярные панели);
- Селективная выдача результатов чувствительности (каскадное тестирование);
- Уведомление о выделении мультирезистентных организмов;
- Консультативная поддержка клиницистов.
Эпидемиологический надзор
Участие в национальных и международных программах:
- GLASS (WHO) — Глобальная система надзора за АМР;
- EARS-Net (ECDC) — Европейская сеть надзора;
- Национальные программы мониторинга;
- Внутрибольничный надзор за резистентностью.
Современные решения для лаборатории
Быстрое определение чувствительности
Новые технологии сокращают время до результата:
- Accelerate Pheno — определение МИК из положительной гемокультуры за 7 часов;
- MALDI-TOF + mbt-ASTRA — быстрое определение резистентности к карбапенемам;
- Непосредственная инокуляция — посев напрямую из положительной гемокультуры.
Цифровые решения
- Лабораторные информационные системы с модулем эпидемиологии;
- Автоматическое формирование антибиограммы;
- Мониторинг паттернов резистентности в реальном времени;
- Интеграция с системами поддержки принятия решений.
Заключение
Клиническая микробиологическая лаборатория — передний край борьбы с антимикробной резистентностью. Своевременная и точная диагностика, мониторинг паттернов резистентности и участие в программах управления антибиотиками — залог эффективного контроля АМР.
KombiMED предлагает оборудование и расходные материалы для микробиологических лабораторий стран Центральной Азии, Кавказа и Восточной Европы — от автоматизированных систем идентификации и определения чувствительности до расходных материалов и контролей. 25+ лет работы с европейскими стандартами качества и полный цикл сопровождения.
Планируете модернизацию микробиологической лаборатории? Свяжитесь с нами для консультации и коммерческого предложения.